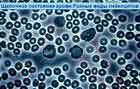

90971 (679601), страница 4
Текст из файла (страница 4)
Комментарий специалиста: автор не знает, что лимфоциты в норме не намного больше эритроцитов(4,7,9,30).
У тромбоцитов, при этом, на большом увеличении, не должно быть отростков (4). Если появляются отростки, то возможна какая-то патология.
Комментарий специалиста: тромбоциты в норме имеют отростки (4,7,9,30).
Для того, чтобы определить состояние человеческого организма – необходимо оценить состояние плазмы. У всех людей от 18 и моложе кровь должна быть именно такая. Потому, что у молодых людей в организме находится естественный резерв минералов.
Слайд № 3. Когда мы становимся старше, среда организма сдвигается в более кислую сторону и появляются монетные столбики. Две стрелочки показывают на эритроциты, которые только что появились. На них еще не успела повлиять повышенная кислотность окружающей среды. Так, как она уже повлияла на все остальные эритроциты.
То, что вы можете предварительно оценить – так это уровень кислотности этого человека. Именно по наличию и состоянию монетных столбиков (по тому насколько они длиннее или короче). Наша кровь всегда щелочная. Когда рН у нас уменьшается до уровня 7,3 (это минимальное состояние pН крови), в крови обнаруживается большое количество монетных столбиков. Главная проблема заключается в том, что когда они появляются, то резко снижается способность эритроцитов переносить кислород. Эритроциты, которые являются частью монетных столбиков, могут нести только 20% от того количества кислорода, которое несут отдельно лежащие здоровые эритроциты. У разделенных между собой эритроцитов соответственно большая возможность забирать через большую поверхность кислород. При образовании монетных столбиков у эритроцитов просто нет физической возможности и достаточной поверхности, для того, чтобы впитывать кислород. Главная функция эритроцитов - это доставлять кислород другим клеткам нашего организма, поэтому сокращение на 80% их возможностей, безусловно, повлияет на все виды обмена у человека. При том что, рН крови этого человека смещена в кислое состояние, все-таки состояние плазмы чистое и необратимых изменений нет, т.е. этому человеку нетрудно будет помочь. Длина монетных столбиков сразу может дать ответ, без определения на приборах, насколько кислотность крови близка к предельно низкому состоянию 7,35.
Эритроциты живут 120 дней, и примерно каждую минуту наш организм производит 2 миллиарда эритроцитов. К сожалению, часть из них не будет в идеальном состоянии.
|
|
|
| ||
| Слайд №4 | Слайд №5 | Слайд №6 |
Слайд № 4. Существуют некоторые показатели, которые могут вам помочь увидеть клетки эритроцитов в состоянии анемии. Это эритроциты маленького размера и более бледные по окраске (1). Не бойтесь, если вы увидите в поле зрения один или два таких эритроцита, но когда вы видите 10-12 измененных эритроцитов в каждом новом поле зрения, то это большей частью говорит об анемии. Иногда вам настолько интересно рассказать все, что вы видите, что это пугает клиента. Он подскакивает на стуле с криками: «Ох! У меня есть анемическая клетка?». Диагноз – это все, что он слышит.
Комментарий специалиста: главное запугать…
Слайд № 5. Когда вы видите агрегацию тромбоцитов (1), то это еще не значит, что это пляж. Вам нужно внимательно посмотреть существует ли мембрана, которая их окружает. Потому, что когда тромбоциты взрослеют, у них есть мембрана, через какое-то время они расходятся. Вам надо посмотреть не находится ли рядом отдельно взятый тромбоцит (2). Если вы видите много тромбоцитов в склеенном состоянии, то это сигнал для вас, что есть какая-то проблема с костной тканью.
Комментарий специалиста: повреждение капилляров при проколе пальца, а также контакт крови со стеклом запускают реакцию тромбообразования. Никакой прямой связи между тромбоцитами и костной тканью нет (7,9,11,12).
Вам надо обязательно фокусировать микроскоп, для того чтобы видеть реальную, четкую картинку состояния тромбоцитов. Кислотность крови не влияет на их состояние.
Слайд № 6. Это лейкоцит (1), который в норме должен быть гораздо большего размера, но из-за того, что кровь настолько закислена, он стал меньше. Лейкоцит в таком состоянии не активен и иммунная система у пациента, безусловно, подавлена. У меня есть много знакомых врачей, которые посылают клиентов с вопросом: «У этого клиента большое количество лейкоцитов, почему он болен?» И когда я смотрю их кровь, оказывается, что из-за того, что она в очень закисленном состоянии, лейкоциты не являются активными. Даже, при их большом количестве иммунная система просто не работает.
Леонид Лапп: Во всех книжках написано, что кровь у нас постоянно в щелочном состоянии 7,35 – 7,45, она не может быть кислой, но оказывается оптимальный вариант для крови - это 7,45 (максимальная цифра) а когда мы говорим о состоянии крови в закисленном состоянии, то речь идет о крови 7,35.
Слайд № 7. Состояние крови, когда длина монетных столбиков небольшая и, не смотря на то, что существует определенный уровень кислотности (это не оптимальный вариант), но кровь, безусловно, в значительно лучшем состоянии. В серединке лейкоцит в хорошем состоянии (1) – это закисленность среднего уровня с активным лейкоцитом. Вот эта клетка (2) – очень старый эритроцит. Я бы для себя сделал следующее определение, что практически это кровь достаточно щелочная. Такая ситуация может произойти у любого здорового человека после физических упражнений. Или у того человека, который пробежался по ступенькам своего дома. Важно концентрироваться не только на эритроцитах, но и обязательно смотреть состояние лейкоцитов и плазмы. Очень часто, когда люди работают с темнопольным микроскопом, обращают большое внимание на эритроциты, но не внимательно смотрят на все остальные компоненты.
Вопрос из зала. В каком соотношении должно быть количество нейтрофилов и лейкоцитов?
Курт Грейндж. 500 на 100 тысяч.
Комментарий специалиста: нейтрофилы – это и есть лейкоциты, в норме 50 – 72% всех лейкоцитов и, примерно 1-2 лейкоцита на 1000 эритроцитов, так что названные цифры отображают неграмотность специалиста (7,9,12,30).
|
|
|
| ||
| Слайд №7 | Слайд №8 | Слайд №9 |
Слайд № 8. На этом слайде мы видим великолепную картинку четырех видов лейкоцитов (нейтрофил (1); лимфоцит (2); бластофил (3); эозинофил (4)). Если вы видите большое количество лейкоцитов вместе, вы должны подумать о том, что это вариант возможной инфекции. Очень важно, какой тип лейкоцитов вы видите. Макрофаги обычно работают вне крови. Они в активном состоянии разрушают вирусы, бактерии и другие патогенные включения. Поэтому, когда много макрофагов в крови, это значит, что там происходит, что-то серьезное.
Комментарий специалиста: термин «бластофил» отсутствует в какой-либо классификации (4,7,9,12,30).
В принципе это не большая группа и это ничего не значит. Для того, чтобы сделать вывод о более серьезных процессах, вам нужно увидеть много таких групп. В любом случае, если у вас появляется сомнение или хотя бы элемент сомнения, обязательно возьмите образец крови еще раз.
Слайд № 9. Здесь щелочная кровь с активным лейкоцитом – это его макрофаговое состояние -Т-клетка (1). Я иногда бываю настолько поражен белыми лейкоцитами, их работой, что я просто застываю и смотрю на них. К сожалению, большинство врачей этого не видят потому, что у них «мертвые слайды», они не могут этого видеть.
Обратите внимание на хвостатые клеточки, мы называем это белковый хвост (2). Это значит, что пищеварительные ферменты не разрушают полностью белок.
Комментарий специалиста: в задачу Т-лимфоцитов не входит переваривание, их задача специализированно-иммунная(4,7,9,12,30).
|
|
|
| ||
| Слайд №10 | Слайд №11 | Слайд №12 |
Слайд № 10. Это нейтрофил и эритроциты в идеальном состоянии.
Комментарий специалиста: любопытно, что фотографии сделаны с разным увеличением, но ни на одном не указано увеличение.
Слайд № 11. Бывают такие моменты, когда вы видите клетки в виде «ёжиков» - это токсины. Это не обязательно является конкретным токсином, но это доказательство того, что токсины в организме существуют. Некоторые эритроциты являются следствием воздействия токсинов (1). Но, учитывая, что еще ни один человек не занимался этим серьезно, мы стараемся не характеризовать это более точно. Поэтому вместо того чтобы сказать, что это кусочек свинца или какого-то другого токсического металла, который может находиться в пище, в воздухе, будет проще сказать, что это является результатом присутствия или наличия токсинов в организме. Вам необходимо помнить, о том, что вместилищем токсинов будет либо печень, либо живая клетка. А это значит, что человека надо очистить. Обязательно спросите о профессии вашего клиента. Если это домашняя хозяйка, то сделайте акцент на то – какими, и в каком количестве химикатами, она пользуется в домашнем хозяйстве. Очень часто маляры и маникюрши, имеют кровь именно в таком состоянии. Вам очень захочется при виде такого снимка определить болезнь, но необходимо найти причину заболевания.
Сейчас в связи с тем, что в США - страховая медицина, то у каждого врача, который работает на государственной службе, получает зарплату от страховых компаний - есть определенные пределы: 12 мин для клиента. Это вынуждает доктора лечить симптом, а не искать причину.
Комментарий специалиста: т.е. автор не знает природу этого явления и, узнав о вредных факторах на производстве у пациента – уверенно говорит об отравлении исследуемого. Молекулы токсинов невозможно увидеть при таком увеличении.
Слайд № 12. Эритроциты, повреждённые свободными радикалами (1) и дрожжевая инфекция (2). Если стеклышко с кровью у вас лежит дольше 15 мин., то в этом случае, у вас начнется попадание воздуха и искажение результата.
Я прошу не забывать, что кандида живет в толстом кишечнике и это очень важно. Если клиент получил в своей жизни большую дозу антибиотиков или много ест белой муки или белого рафинированного сахара, то происходит следующее: во-первых, это является прекрасным питанием для спор кандиды; во-вторых, это позволяет кандиде разрастаться настолько, что она покидает кишечник и перемещается в другие органы. Вы не можете видеть кандиду в крови, это только её споры. Если вы, не дай Бог, увидели кандиду в крови, то этот человек умер. Если у человека споры кандиды в крови - у него очень серьёзные проблемы, это значит, она уже прорастает в ткани. Для того, чтобы расти и размножаться, кандида ворует питание у наших органов. Обычно это не является самой болезнью, а является дополнением к синдрому хронической усталости. Ну а когда кандида уже хорошо поела, у нее есть возможность размножаться. Клинически - это очень похоже на грипп. Продукция, которая является следствием размножения кандиды - это токсины. Что происходит: токсины стимулируют болевые рецепторы. Там, где происходит разрастание кандиды – это слабое место для данного человека. Это обычно: спина, суставы, горло. Процесс размножения кандиды может вызывать такую болезнь как фибромиалгия. Но если организм находится в щелочном состоянии, для кандиды практически нет возможности размножаться.
Комментарий специалиста: правда только в том что у живого человека кандида не может находиться в крови ни в каком состоянии (17,20).
Чтобы помочь пациенту, первым делом надо убрать источник питания для кандиды – это белая мука, белый сахар и антибиотики. И только после этого мы можем начать работу над лечением. Делаем коктейль кораллового кальция и коллоидного серебра. Я беру стакан воды и бросаю пакетик «Алка-Майн», он там должен быть в течение 15 мин. Это нужно выпить первым делом утром. После того как человек это выпил, возьмите уже использованный и новый пакетик и положите в бутылку размером между 1,5 и 2 литрами. Я обычно капаю 20 капель серебра в эту бутылку. И обязательно еще чайную ложку серебра под язык (держать не менее двух минут), делать это утром и вечером. Если ситуация тяжелая, запущенная – делайте это чаще. Когда происходит процесс умирания кандиды, в этот момент у человека будет большое количество проблем. Вы знаете такую проблему как очистительный кризис, не надо этого бояться. Добавьте больше воды и тогда это поможет вашему клиенту пройти процесс очистительного кризиса. Необходимо также проконсультировать вашего клиента по поводу режима питания. Я, например, составляю меню для этого клиента. Как минимум на 3 недели, необходимо на 100% ограничить те 5 вещей, о которых мы говорили в самом начале: мука, сахар, все газированные напитки, сигареты и аспартам (искусственные подсластители). А лучше этого придерживаться 6 месяцев.
Вопрос из зала. А как часто надо проверять кровь?
Курт Грейндж. Я бы проверял каждые 10 дней для контроля лечения. Но, конечно, это зависит от состояния данного конкретного клиента.